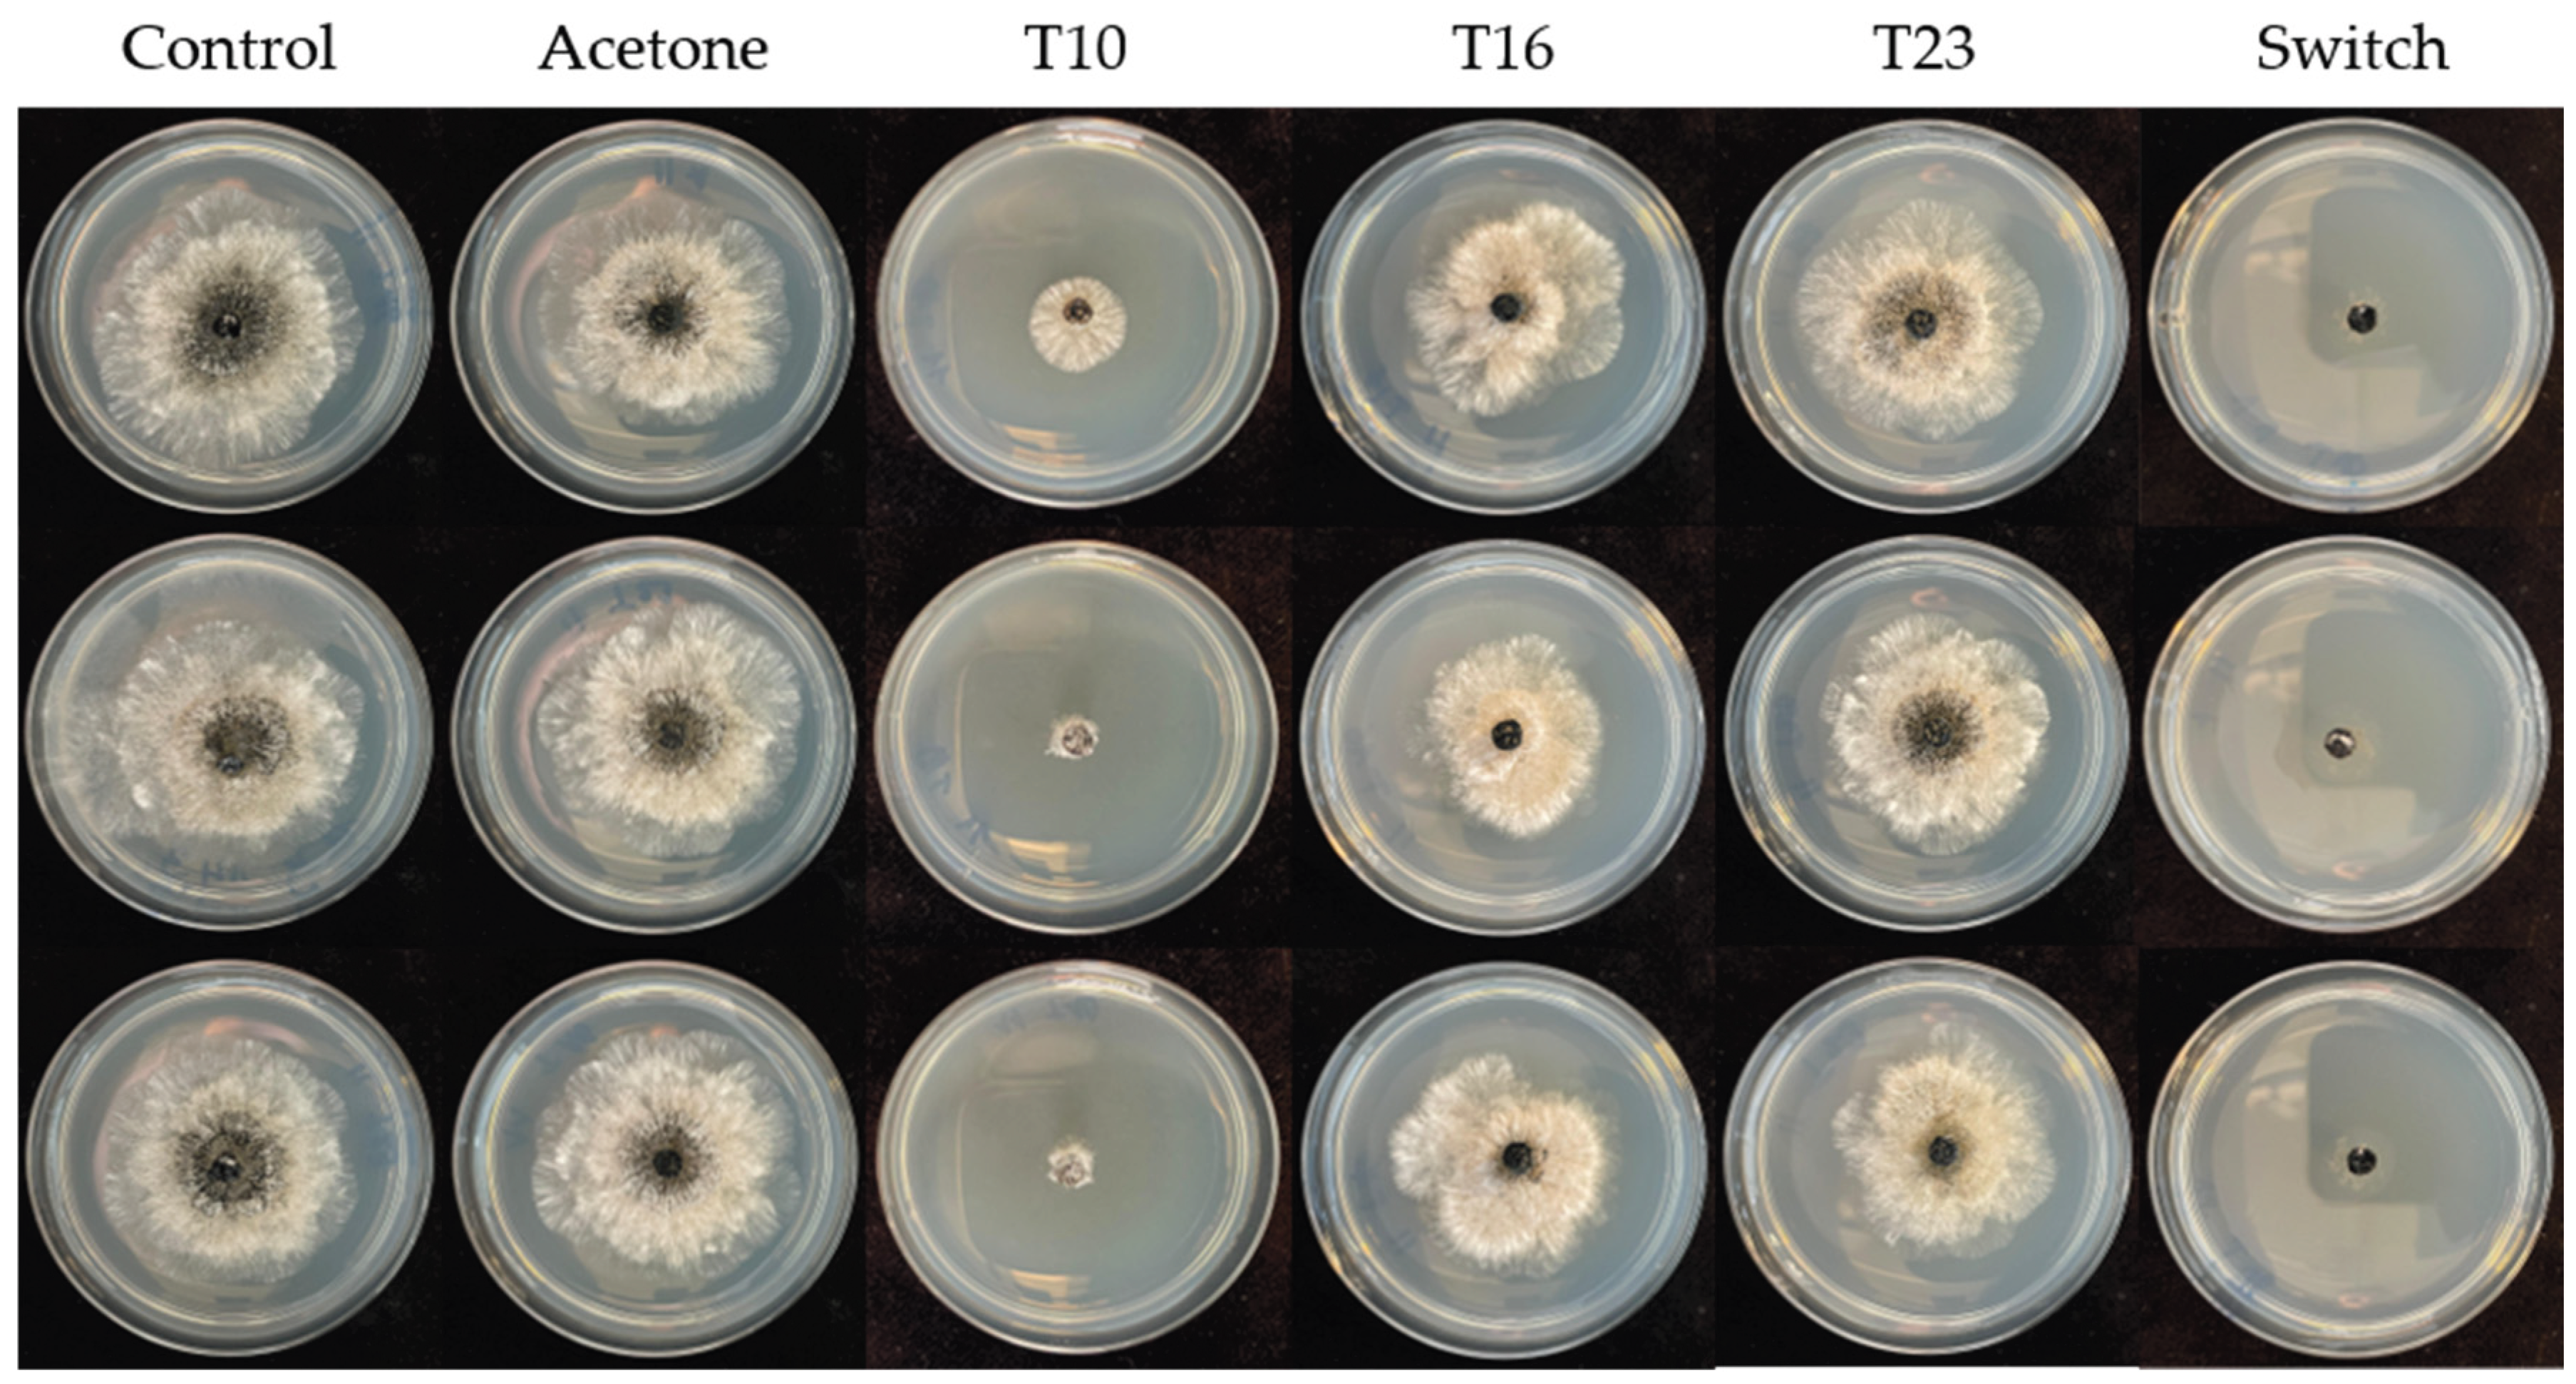
Preprints 197845 g0a1

Submitted:
06 February 2026
Posted:
09 February 2026
You are already at the latest version
Abstract
Neopestalotiopsis rosae is an emerging fungal pathogen causing leaf blight and fruit rot on strawberry. Due to limited fungicide availability and the small number of substances confirmed to be effective against this pathogen, alternative disease control strategies have become a focus of current research. This study aimed to assess, quantify and compare the efficacy of extracts and inocula of Trichoderma spp. with the conventional fungicide Switch in controlling N. rosae. While T. harzianum T16 and T. asperellum T23 extracts showed moderate inhibitory effects against N. rosae, T. koningiopsis T10 extracts were able to inhibit mycelial growth and conidia germination as effectively as the reference fungicide. Under greenhouse conditions, extracts from T. koningiopsis T10 were as effective as Switch in controlling leaf spots incited by N. rosae. Our findings highlight T. koningiopsis T10 extracts as a promising alternative to chemical fungicides in the integrated management of N. rosae on strawberry.
Keywords:
1. Introduction
2. Materials and Methods
2.1. Micobial and Plant Materials
2.2. Preparation of Conidial Suspensions from Trichoderma spp. and N. rosae
2.3. Extraction of Secondary Metabolites from Trichoderma spp.
2.4. Bioautography Assay
2.5. Poisoned Agar Plug Assay
2.6. Inhibition of Conidia Germination of N. rosae
2.7. Greenhouse Trial
2.8. Statistical Analysis
3. Results
3.1. Mycelial Growth Inhibition of N. rosae on TLC Plates Amended with Trichoderma Extracts
3.2. Poisoned Agar Plug Assay
3.3. Inhibition of Conidia Germination of N. rosae by Trichoderma Crude Extracts
3.4. In Planta Assesment of the Effects of Crude Extracts and Conidia of Trichoderma spp. Against N. rosae
4. Discussion
5. Conclusions
Author Contributions
Funding
Data Availability Statement
Acknowledgments
Conflicts of Interest
Abbreviations
| ANOVA | Analysis of Variance |
| ANCOVA | Analysis of Covariance |
| AUDPC | Area Under The Disease Progress Curve |
| BCA | Biological Control Agent |
| EtOAc | Ethyl acetate |
| GM7 | Glucose-Medium-7 |
| IPM | Integrated Pest Management |
| LSD | Least Significant Difference |
| MDPI | Multidisciplinary Digital Publishing Institute |
| MTT | 2-(3,5-diphenyltetrazol-2-ium-2-yl)-4,5-dimethyl-1,3-thiazole bromide |
| rAUDPC | Relative Area Under The Disease Progress Curve |
| 6 PAP | 6-pentyl-alpha-pyrone |
Appendix A
Poisoned Agar Plug Assay with N. rosae
References
- Ávila-Hernández, J.G.; León-Ramírez, C.G.; Abraham-Juárez, M. del R.; Tlapal-Bolaños, B.; Olalde-Portugal, V.; Délano-Frier, J.P.; Martínez-Antonio, A.; Aguilar-Zárate, P. Neopestalotiopsis Spp.: A Threat to Strawberry Production and Management. Horticulturae 2025, 11, 288. [Google Scholar] [CrossRef]
- Simpson, D. The Economic Importance of Strawberry Crops. In The Genomes of Rosaceous Berries and Their Wild Relatives; Hytönen, T., Graham, J., Harrison, R., Eds.; Springer International Publishing: Cham, 2018; pp. 1–7. ISBN 978-3-319-76020-9. [Google Scholar]
- Rajnish, K.; Gautam, H.R. Prevalence and Management of Pestalotia Leaf Spot (Pestalotia sp.) of Strawberry. International Journal of Economic Plants 2022, 9, 250–254. [Google Scholar] [CrossRef]
- Garrido, C.; González-Rodríguez, V.E.; Carbú, M.; Husaini, A.M.; Cantoral, J.M. Fungal Diseases of Strawberry and Their Diagnosis. In Strawberry: Growth, Development and Diseases; Husaini, A.M., Neri, D., Eds.; Cabi Publishing: Wallingford, UK, 2016; pp. pp. 157–195. ISBN 978-1-78064-663-3. [Google Scholar]
- Schierling, T.E.; Voegele, R.T.; El-Hasan, A. First Report on the Emergence of Neopestalotiopsis Rosae as a Severe Economic Threat to Strawberry Production in Germany. Microorganisms 2025, 13, 6. [Google Scholar] [CrossRef] [PubMed]
- Xiong, J.; Peng, S.; Liu, Y.; Yin, H.; Zhou, L.; Zhou, Z.; Tan, G.; Gu, Y.; Zhang, H.; Huang, J.; Meng, D. Soil Properties, Rhizosphere Bacterial Community, and Plant Performance Respond Differently to Fumigation and Bioagent Treatment in Continuous Cropping Fields. Frontiers in Microbiology 2022, 13, 923405. [Google Scholar] [CrossRef]
- Zhang, S.; Wu, J.; Chen, J.; Jun, S.; Yuan, Y.; Dai, X.; Wang, F.; Ma, Y. The Biological Control Effect of Bacillus cereus on Strawberry Leaf Spot Disease Caused by Neopestalotiopsis clavispora. Scientia Horticulturae 2024, 327, 112841. [Google Scholar] [CrossRef]
- Aljawasim, B.D.; Samtani, J.B.; Rahman, M. New Insights in the Detection and Management of Anthracnose Diseases in Strawberries. Plants 2023, 12, 3704. [Google Scholar] [CrossRef] [PubMed]
- Chung, P.-C.; Wu, H.-Y.; Wang, Y.-W.; Ariyawansa, H.A.; Hu, H.-P.; Hung, T.-H.; Tzean, S.-S.; Chung, C.-L. Diversity and Pathogenicity of Colletotrichum Species Causing Strawberry Anthracnose in Taiwan and Description of a New Species, Colletotrichum miaoliense sp. nov. Scientific Reports 2020, 10, 14664. [Google Scholar] [CrossRef]
- Gunnell, P.S.; Gubler, W.D. Taxonomy and Morphology of Colletotrichum Species Pathogenic to Strawberry. Mycologia 1992, 84, 157–165. [Google Scholar] [CrossRef]
- Koike, S.T.; Gordon, T.R. Management of Fusarium Wilt of Strawberry. Crop Protection 2015, 73, 67–72. [Google Scholar] [CrossRef]
- Basu, P.K. Verticillium Disease of Strawberries. Canadian Journal of Botany 1961, 39, 165–196. [Google Scholar] [CrossRef]
- Baggio, J.S.; Rebello, C.S.; de Morais, M.B.; Marin, M.V.; Gama, A.B.; Forcelini, B.B.; Mertely, J.C.; Peres, N.A. Efficacy of Single- and Multi-Site Fungicides Against Neopestalotiopsis spp. of Strawberry. Plant Disease 2023, 107, 2177–2184. [Google Scholar] [CrossRef]
- Essa, T.A.; Kamel, S.M.; Ismail, A.M.; El-Ganainy, S. Characterization and Chemical Control of Neopestalotiopsis rosae the Causal Agent of Strawberry Root and Crown Rot in Egypt. Egyptian Journal of Phytopathology 2018, 46, 1–19. [Google Scholar] [CrossRef]
- Rebollar-Alviter, A.; Silva-Rojas, H.V.; Fuentes-Aragón, D.; Acosta-González, U.; Martínez-Ruiz, M.; Parra-Robles, B.E. An Emerging Strawberry Fungal Disease Associated with Root Rot, Crown Rot and Leaf Spot Caused by Neopestalotiopsis rosae in Mexico. Plant Disease 2020, 104, 2054–2059. [Google Scholar] [CrossRef]
- Ara, M.; Monzur, S.; Saand, M.; Islam, R.; Alam, S.; Hossain, M. The First Report of Pestalotiopsis sp. Causing Crown Rot Disease on Strawberry (Fragaria X ananassa Duch.) in Bangladesh and Evaluation of Fungicide Activity. International Journal of Biosciences 2017, 11, 350–358. [Google Scholar]
- Baggio, J.S.; Forcelini, B.B.; Wang, N.-Y.; Ruschel, R.G.; Mertely, J.C.; Peres, N.A. Outbreak of Leaf Spot and Fruit Rot in Florida Strawberry Caused by Neopestalotiopsis spp. Plant Disease 2021, 105, 305–315. [Google Scholar] [CrossRef]
- Chandana, R.; Poonacha, T.T.; Chethan, D.; Karan, R.; Kruthika, R.; Khan, F.; Ashwini, K.S.; Bevanur, A.; Vani, Y.; Ramesh, G.V.; Palanna, K.B. Neopestalotiopsis rosae, a Novel Pathogen Causing Leaf Blight and Crown Rot of Strawberries in India. Physiological and Molecular Plant Pathology 2024, 133, 102377. [Google Scholar] [CrossRef]
- Kaur, H.; Gelain, J.; Marin, M.V.; Peres, N.A.; Schnabel, G. Development of a Molecular Tool for Identification of a New Neopestalotiopsis sp. Associated with Disease Outbreaks on Strawberry. Plant Disease 2023, 107, 1544–1549. [Google Scholar] [CrossRef]
- Sun, Q.; Harishchandra, D.; Jia, J.; Zuo, Q.; Zhang, G.; Wang, Q.; Yan, J.; Zhang, W.; Li, X. Role of Neopestalotiopsis rosae in Causing Root Rot of Strawberry in Beijing, China. Crop Protection 2021, 147, 105710. [Google Scholar] [CrossRef]
- Rotondo, F.; Klass, T.L.; Scott, K.; McCartney, M.; Jacobs, J.M.; Lewis Ivey, M.L. First Report of Neopestalotiopsis Disease in Ohio Caused by an Emerging and Novel Species of Neopestalotiopsis on Strawberry. Plant Disease 2023, 107, 940. [Google Scholar] [CrossRef]
- Bund. Verzeichnis Zugelassener Pflanzenschutzmittel. Available online: https://psm-zulassung.bvl.bund.de/psm/jsp/ (accessed on 9 October 2025).
- Gupta, R.C; Gupta, P.K. Chapter 45 - Toxicity of Fungicides. In Veterinary Toxicology (Third Edition); Gupta, R.C., Ed.; Academic Press: London, UK, 2025; pp. 581–593. ISBN 978-0-12-811410-0. [Google Scholar]
- Amiri, A.; Heath, S.M.; Peres, N.A. Phenotypic Characterization of Multifungicide Resistance in Botrytis cinerea Isolates from Strawberry Fields in Florida. Plant Disease 2013, 97, 393–401. [Google Scholar] [CrossRef]
- Forcelini, B.B.; Seijo, T.E.; Amiri, A.; Peres, N.A. Resistance in Strawberry Isolates of Colletotrichum acutatum from Florida to Quinone-Outside Inhibitor Fungicides. Plant Disease 2016, 100, 2050–2056. [Google Scholar] [CrossRef]
- Karuppuchamy, P.; Venugopal, S. Integrated Pest Management. In Ecofriendly Pest Management for Food Security; Omkar, Ed.; Academic Press: San Diego, 2016; pp. 651–684. ISBN 978-0-12-803265-7. [Google Scholar]
- Stenberg, J.A. A Conceptual Framework for Integrated Pest Management. Trends in Plant Science 2017, 22, 759–769. [Google Scholar] [CrossRef]
- Ghisalberti, E.L.; Rowland, C.Y. Antifungal Metabolites from Trichoderma harzianum. Journal of Natural Products 1993, 56, 1799–1804. [Google Scholar] [CrossRef]
- El-Hasan, A.; Walker, F.; Schöne, J.; Buchenauer, H. Antagonistic Effect of 6-Pentyl-Alpha-Pyrone Produced by Trichoderma harzianum toward Fusarium moniliforme. Journal of Plant Disease and Protection 2007, 114, 62–68. [Google Scholar] [CrossRef]
- Abbey, J.A.; Percival, D.; Abbey, Lord; Asiedu, S.K.; Prithiviraj, B.; Schilder, A. Biofungicides as Alternative to Synthetic Fungicide Control of Grey Mould (Botrytis cinerea) – Prospects and Challenges. Biocontrol Science and Technology 2019, 29, 207–228. [Google Scholar] [CrossRef]
- Anand, T.; Chandrasekaran, A.; Kuttalam, S.; Senthilraja, G.; Samiyappan, R. Integrated Control of Fruit Rot and Powdery Mildew of Chilli Using the Biocontrol Agent Pseudomonas fluorescens and a Chemical Fungicide. Biological Control 2010, 52, 1–7. [Google Scholar] [CrossRef]
- Jochum, C.C.; Osborne, L.E.; Yuen, G.Y. Fusarium Head Blight Biological Control with Lysobacter enzymogenes Strain C3. Biological Control 2006, 39, 336–344. [Google Scholar] [CrossRef]
- Vinale, F.; Sivasithamparam, K.; Ghisalberti, E.L.; Marra, R.; Woo, S.L.; Lorito, M. Trichoderma–Plant–Pathogen Interactions. Soil Biology and Biochemistry 2008, 40, 1–10. [Google Scholar] [CrossRef]
- Benítez, T.; Rincón, A.M.; Limón, M.C.; Codón, A.C. Mecanismos de Biocontrol de Cepas de Trichoderma. International Microbiology 2004, 7, 249–260. [Google Scholar]
- Verma, M.; Brar, S.K.; Tyagi, R.D.; Surampalli, R.Y.; Valéro, J.R. Antagonistic Fungi, Trichoderma spp.: Panoply of Biological Control. Biochemical Engineering Journal 2007, 37, 1–20. [Google Scholar] [CrossRef]
- Gruber, S.; Seidl-Seiboth, V. Self versus Non-Self: Fungal Cell Wall Degradation in Trichoderma. Microbiology 2012, 158, 26–34. [Google Scholar] [CrossRef]
- Schierling, T.E.; Vogt, W.; Voegele, R.T.; El-Hasan, A. Efficacy of Trichoderma spp. and Kosakonia sp. Both Independently and Combined with Fungicides against Botrytis cinerea on Strawberries. Antibiotics 2024, 13, 912. [Google Scholar] [CrossRef] [PubMed]
- Schuster, A.; Schmoll, M. Biology and Biotechnology of Trichoderma. Applied Microbiology and Biotechnology 2010, 87, 787–799. [Google Scholar] [CrossRef] [PubMed]
- Steyaert, J.M.; Ridgway, H.J.; Elad, Y.; Stewart, A. Genetic Basis of Mycoparasitism: A Mechanism of Biological Control by Species of Trichoderma. New Zealand Journal of Crop and Horticultural Science 2003, 31, 281–291. [Google Scholar] [CrossRef]
- Mukherjee, P.K.; Mendoza-Mendoza, A.; Zeilinger, S.; Horwitz, B.A. Mycoparasitism as a Mechanism of Trichoderma-Mediated Suppression of Plant Diseases. Fungal Biology Reviews 2022, 39, 15–33. [Google Scholar] [CrossRef]
- Nawrocka, J.; Małolepsza, U. Diversity in Plant Systemic Resistance Induced by Trichoderma. Biological Control 2013, 67, 149–156. [Google Scholar] [CrossRef]
- Bisen, K.; Keswani, C.; Patel, J.S.; Sarma, B.K.; Singh, H.B. Trichoderma spp.: Efficient Inducers of Systemic Resistance in Plants. In Microbial-mediated Induced Systemic Resistance in Plants; Choudhary, D.K., Varma, A., Eds.; Springer Nature: Singapore, 2016; pp. 185–195. ISBN 978-981-10-0388-2. [Google Scholar]
- Sivan, A.; Chet, I. Degradation of Fungal Cell Walls by Lytic Enzymes of Trichoderma harzianum. Microbiology 1989, 135, 675–682. [Google Scholar] [CrossRef]
- Metcalf, D.A.; Wilson, C.R. The Process of Antagonism of Sclerotium cepivorum in White Rot Affected Onion Roots by Trichoderma koningii. Plant Pathology 2001, 50, 249–257. [Google Scholar] [CrossRef]
- Santos, A.J.C.; Divina, C.C.; Pineda, F.G. In Vitro Evaluation of the Antagonistic Activity of Trichoderma sp. against Fusarium verticillioides. International Journal of Agricultural Technology 2017, 13, 2539–2548. [Google Scholar]
- El-Hasan, A.; Schöne, J.; Höglinger, B.; Walker, F.; Voegele, R.T. Assessment of the Antifungal Activity of Selected Biocontrol Agents and Their Secondary Metabolites against Fusarium graminearum. European Journal of Plant Pathology 2018, 150, 91–103. [Google Scholar] [CrossRef]
- Vinale, F.; Sivasithamparam, K.; Ghisalberti, E.L.; Woo, S.L.; Nigro, M.; Marra, R.; Lombardi, N.; Pascale, A.; Ruocco, M.; Lanzuise, S.; Manganiello, G.; Lorito, M. Trichoderma Secondary Metabolites Active on Plants and Fungal Pathogens. The Open Mycology Journal 2014, 8, 127–139. [Google Scholar] [CrossRef]
- Vinale, F.; Marra, R.; Scala, F.; Ghisalberti, E.L.; Lorito, M.; Sivasithamparam, K. Major Secondary Metabolites Produced by Two Commercial Trichoderma Strains Active against Different Phytopathogens. Letters in Applied Microbiology 2006, 43, 143–148. [Google Scholar] [CrossRef] [PubMed]
- Hermosa, R.; Cardoza, R.E.; Rubio, M.B.; Gutiérrez, S.; Monte, E. Secondary Metabolism and Antimicrobial Metabolites of Trichoderma. In Biotechnology and Biology of Trichoderma; Gupta, V.K., Schmoll, M., Herrera-Estrella, A., Upadhyay, R.S., Druzhinina, I., Tuohy, M.G., Eds.; Elsevier: Amsterdam, NL, 2014; pp. 125–137. ISBN 978-0-444-59576-8. [Google Scholar]
- Keswani, C.; Mishra, S.; Sarma, B.K.; Singh, S.P.; Singh, H.B. Unraveling the Efficient Applications of Secondary Metabolites of Various Trichoderma spp. Applied Microbiology and Biotechnology 2014, 98, 533–544. [Google Scholar] [CrossRef]
- El-Hasan, A. Potential of Trichoderma harzianum Rifai and Its Secondary Metabolites in Controlling Seedling Blight of Maize Incited by Fusarium moniliforme Sheld; Cuvillier Verlag, 2008; ISBN 978-3-7369-2800-8. [Google Scholar]
- El-Hasan, A.; Walker, F.; Klaiber, I.; Schöne, J.; Pfannstiel, J.; Voegele, R.T. New Approaches to Manage Asian Soybean Rust (Phakopsora pachyrhizi) Using Trichoderma spp. or Their Antifungal Secondary Metabolites. Metabolites 2022, 12, 507. [Google Scholar] [CrossRef]
- Khan, R.A.A.; Najeeb, S.; Hussain, S.; Xie, B.; Li, Y. Bioactive Secondary Metabolites from Trichoderma spp. against Phytopathogenic Fungi. Microorganisms 2020, 8, 817. [Google Scholar] [CrossRef] [PubMed]
- Vinale, F.; Sivasithamparam, K.; Ghisalberti, E.L.; Marra, R.; Barbetti, M.J.; Li, H.; Woo, S.L.; Lorito, M. A Novel Role for Trichoderma Secondary Metabolites in the Interactions with Plants. Physiological and Molecular Plant Pathology 2008, 72, 80–86. [Google Scholar] [CrossRef]
- Rieker, M.E.G.; Lutz, M.A.; El-Hasan, A.; Thomas, S.; Voegele, R.T. Hyperspectral Imaging and Selected Biological Control Agents for the Management of Fusarium Head Blight in Spring Wheat. Plants 2023, 12, 3534. [Google Scholar] [CrossRef]
- Forbes, G.A.; Pérez, W.; Adrade-Piedra, J. Field Assessment of Resistance in Potato to Phytophthora infestans: International Cooperators Guide. In International Potato Center; Lima, PE, 2014; ISBN 978-92-9060-440-2. [Google Scholar]
- Maharachchikumbura, S.S.N.; Hyde, K.D.; Groenewald, J.Z.; Xu, J.; Crous, P.W. Pestalotiopsis Revisited. Studies in Mycology 2014, 79, 121–186. [Google Scholar] [CrossRef]
- Elmer, P. a. G.; Reglinski, T. Biosuppression of Botrytis cinerea in Grapes. Plant Pathology 2006, 55, 155–177. [Google Scholar] [CrossRef]
- Vreysen, M.J.B.; Robinson, A.S.; Hendrichs, J.; Kenmore, P. Area-Wide Integrated Pest Management (AW-IPM): Principles, Practice and Prospects. In Proceedings of the Area-Wide Control of Insect Pests; Vreysen, M.J.B., Robinson, A.S., Hendrichs, J., Eds.; Springer Netherlands: Dordrecht, 2007; pp. 3–33. [Google Scholar]
- He, D.; Zhan, J.; Xie, L. Problems, Challenges and Future of Plant Disease Management: From an Ecological Point of View. Journal of Integrative Agriculture 2016, 15, 705–715. [Google Scholar] [CrossRef]
- National Research Council. Ecologically Based Pest Management: New Solutions for a New Century. In National Academic Press; Washington DC, USA, 1996; ISBN 978-0-309-05330-3. [Google Scholar]
- Ramallo, A.; Namen, S.; Salazar, S.; Heredia, A.; Kirschbaum, D. New Approaches for the Sustainable Management of Neopestalotiopsis clavispora, the Causal Agent of Strawberry Crown and Root Rot in Tucumán, Argentina. Revista Agronómica del Noroeste Argentino 2024, 44, 10–14. [Google Scholar] [CrossRef]
- Ning, J.; Ning, T.; Jin, L.; Li, Q.; Niu, Y.; Chen, Z.; Han, C.; Tang, Y.; Deng, C.; Xie, Y.; Zhao, M.; Cui, X.; Li, J. Biocontrol Effects of Bacillus velezensis and Bacillus subtilis against Strawberry Root Rot Caused by Neopestalotiopsis clavispora. Frontiers in Microbiology 2025, 16, 1683291. [Google Scholar] [CrossRef]
- Darapanit, A.; Boonyuen, N.; Leesutthiphonchai, W.; Nuankaew, S.; Piasai, O. Identification, Pathogenicity and Effects of Plant Extracts on Neopestalotiopsis and Pseudopestalotiopsis Causing Fruit Diseases. Scientific Reports 2021, 11, 22606. [Google Scholar] [CrossRef]
- Liu, P.; Yang, R.; Wang, Z.; Ma, Y.; Ren, W.; Wei, D.; Ye, W. Biocontrol Potential of Trichoderma asperellum CMT10 against Strawberry Root Rot Disease. Horticulturae 2024, 10, 246. [Google Scholar] [CrossRef]
- El-Hasan, A.; Walker, F.; Schöne, J.; Buchenauer, H. Detection of Viridiofungin A and Other Antifungal Metabolites Excreted by Trichoderma harzianum Active against Different Plant Pathogens. European Journal of Plant Pathology 2009, 124, 457–470. [Google Scholar] [CrossRef]
- Tran, T.-N.-M.; Vu, N.-B.-D.; Nguyen, M.-H. Antifungal Activity of Essential Oil-Encapsulated Lipid Nanoemulsions against Neopestalotiopsis rosae Causing Leaf Spot on Strawberry. Journal of Plant Diseases and Protection. 2023, 130, 823–832. [Google Scholar] [CrossRef]
- Zhang, S.; Wu, J.; Chen, J.; Jun, S.; Yuan, Y.; Dai, X.; Wang, F.; Ma, Y. The Biological Control Effect of Bacillus cereus on Strawberry Leaf Spot Disease Caused by Neopestalotiopsis clavispora. Scientia Horticulturae 2024, 327, 112841. [Google Scholar] [CrossRef]
- Amrutha, P.; Vijayaraghavan, R. Evaluation of Fungicides and Biocontrol Agents against Neopestalotiopsis clavispora Causing Leaf Blight of Strawberry (Fragaria x ananassa Duch.). International Journal of Current Microbiology and Applied Sciences 2018, 7, 622–628. [Google Scholar] [CrossRef]
- Liu, P.; Yang, R.; Wang, Z.; Ma, Y.; Ren, W.; Wei, D.; Ye, W. Biocontrol Potential of Trichoderma asperellum CMT10 against Strawberry Root Rot Disease. Horticulturae 2024, 10, 246. [Google Scholar] [CrossRef]





Disclaimer/Publisher’s Note: The statements, opinions and data contained in all publications are solely those of the individual author(s) and contributor(s) and not of MDPI and/or the editor(s). MDPI and/or the editor(s) disclaim responsibility for any injury to people or property resulting from any ideas, methods, instructions or products referred to in the content. |
© 2026 by the authors. Licensee MDPI, Basel, Switzerland. This article is an open access article distributed under the terms and conditions of the Creative Commons Attribution (CC BY) license.
